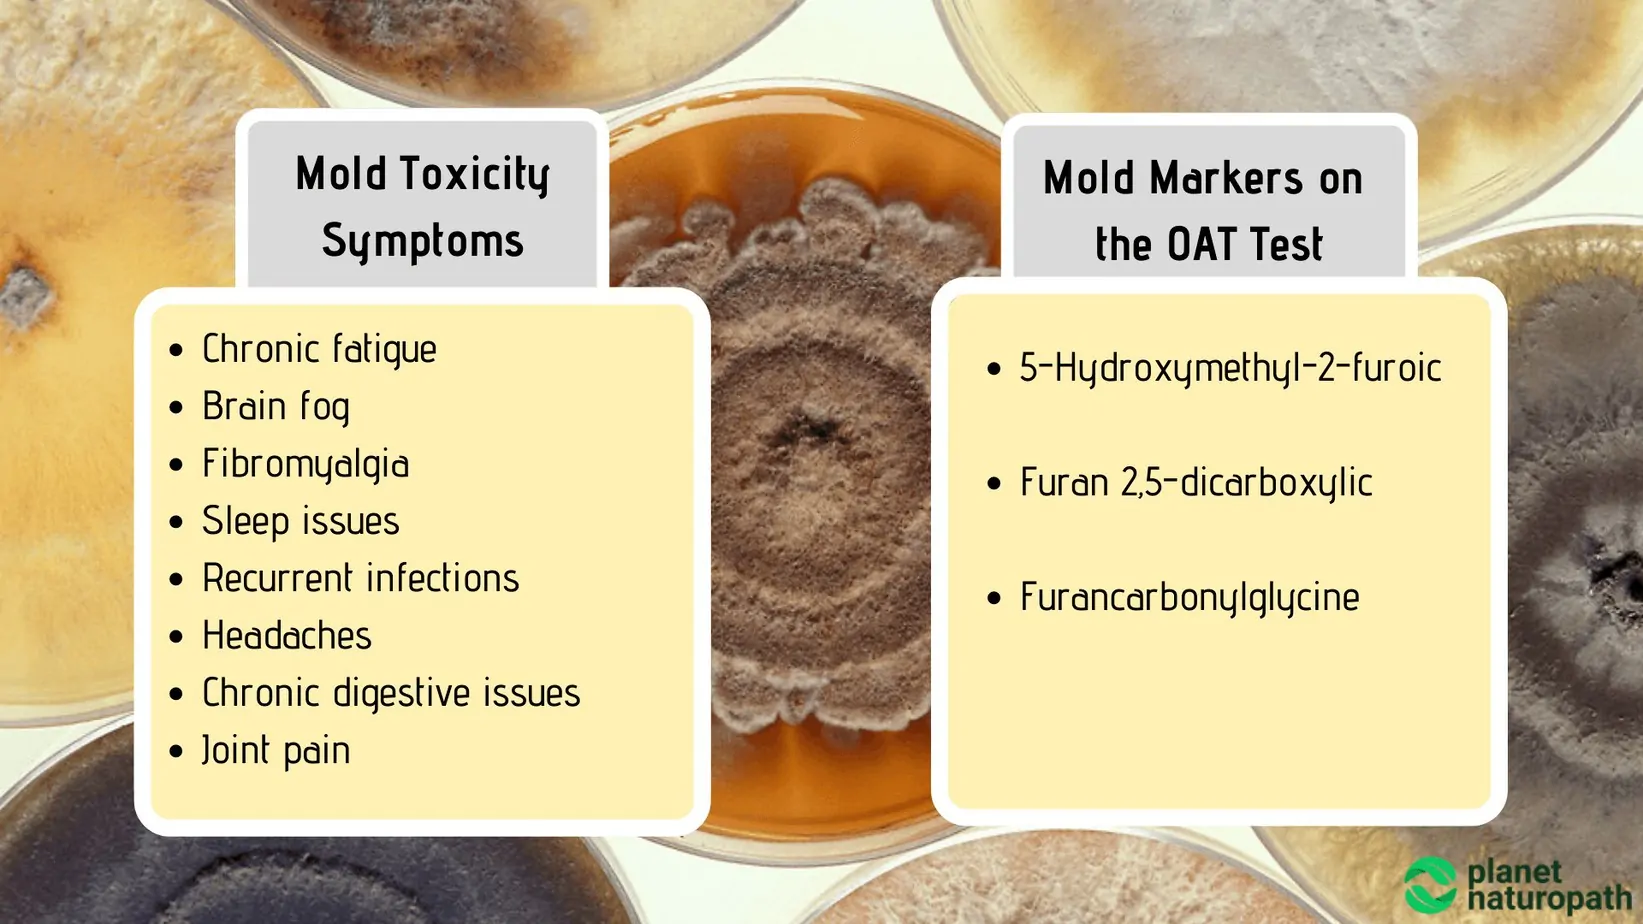
Organic Acid Tests: What It Measures and Why It’s Used? 4 Organic Acid Tests: What It Measures and Why It’s Used? 3
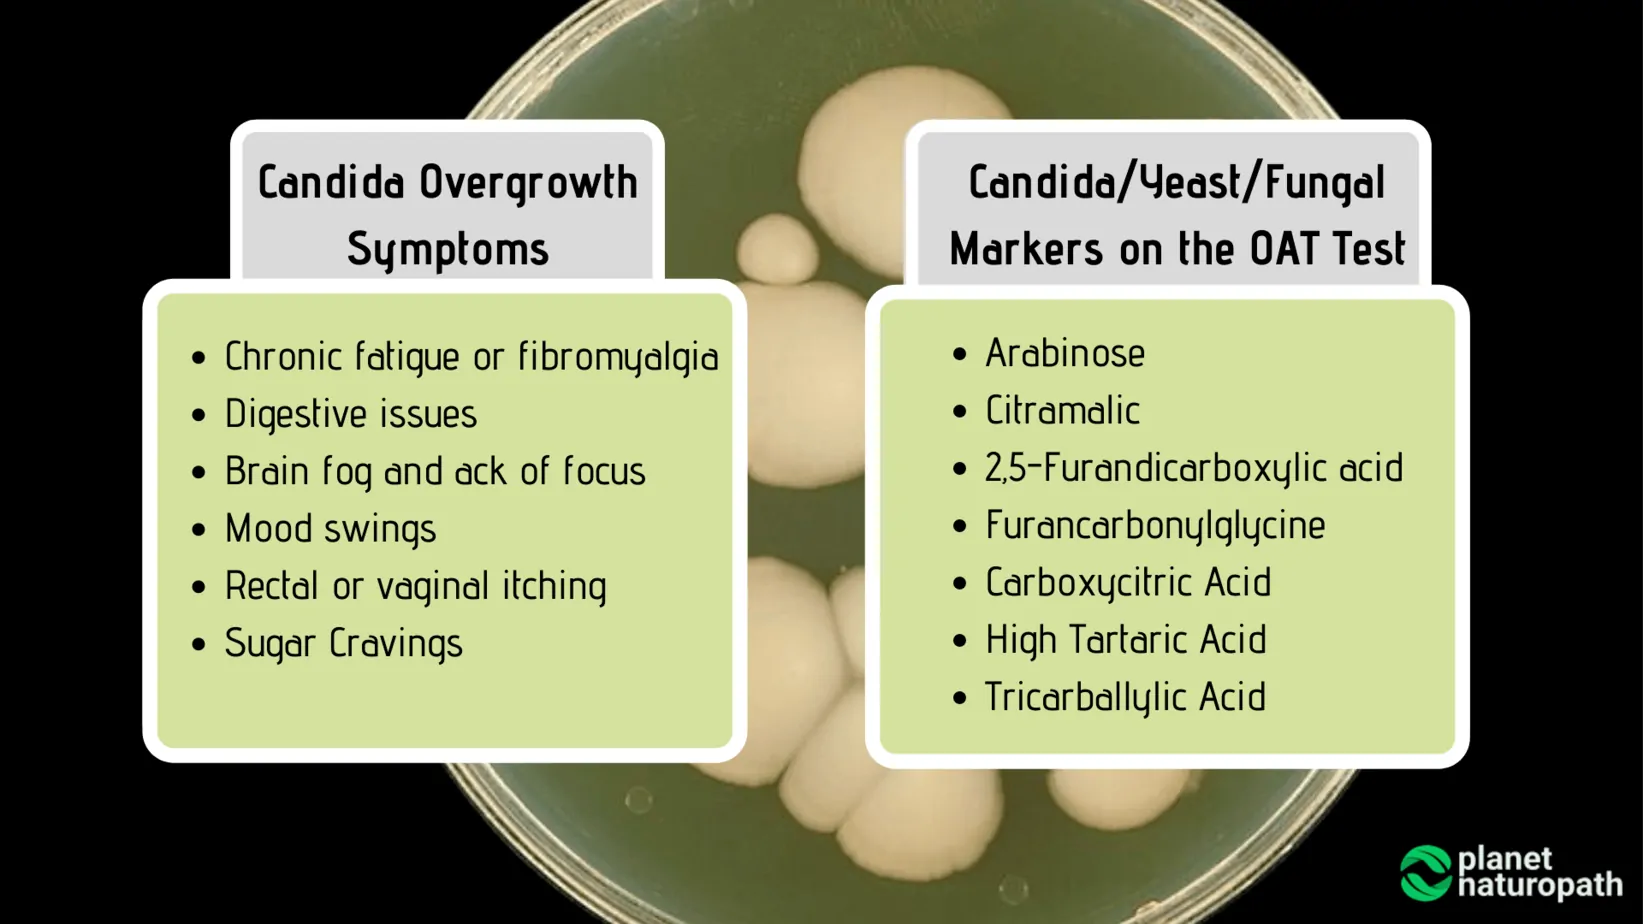
Organic Acid Tests: What It Measures and Why It’s Used? 5 Organic Acid Tests: What It Measures and Why It’s Used? 4

Organic Acid Tests: What It Measures and Why It’s Used?
The Organic Acids Test, commonly called the OAT test is one of my favourite functional medicine tests – this OAT test review will explain why.
Organic acid testing measures 70+ different markers looking at many aspects of your health, and these types of metabolites cannot be tested with standard pathology tests.
So if you have a chronic illness, simply do not “feel quite right” or if you want to optimize your health and performance then Organic Acids testing may be the right option for you. Especially if all of your standard pathology results come back normal.
If you want to order the OAT test read on to see if this type of testing is the best option for you.
The best part is that it only requires a urine sample so it is easy to do with kids, or anyone with a needle phobia.
Table Of Contents
What Is An Organic Acids Test?
If you looked at an Organic Acids Test for the first time you could be forgiven for thinking that it is written in a different language – with names such as 5-Hydroxymethyl-2-furoic, Arabinose, lactic acid and Methylmalonic Acid.
Essentially, organic acids are chemical compounds which are the breakdown products of metabolism in the body, they are excreted in the urine. A block in one of these chemical pathways can either lead to very high levels of organic acids (most common) or lower levels.
These biochemical pathways are very important for energy production, neurotransmitter metabolism, fatty acid metabolism, detoxification, amino acid levels and nutritional status – the results give us invaluable information identifying dysfunction in these areas.
Organic acids are also produced by bacteria, yeast and molds these microorganisms can cause gut issues, candida overgrowth or potential mold toxicity.
This makes organic acid testing a better way of assessing intestinal yeast overgrowth than a stool test, as the stool test only assesses the large intestine.
With the OAT test there are over 70 different markers and you cannot look at each one in isolation, as the results of one marker may influence the meaning of a different organic acid marker.
So while the test gives us a lot of information, what is even more important is that you have a doctor or naturopath who is skilled at interpreting the results and implementing a treatment plan.
I have reviewed 100’s of the OAT test for clients so if you need help with the interpretation Schedule A Consultation
The two main companies that I use for OAT testing are Vibrant Wellness and Mosaic Labs (formerly Great Plains Lab) as their test has a better evaluation of intestinal yeast and bacterial markers, as well as mold metabolites. Another test option is the Genova organix and I can also help you review your Organix results also.
Organic acid testing was originally developed to assess inborn errors of metabolism and genetic disorders, it is a urine test using mass spectrometry and chromatography to separate the acids for analysis.
However, now we can use this advanced testing to assess many aspects of our health.
Who Should Do The Organic Acids Test?

The OAT test is one of my favorite tests and one that I recommend to many clients as it can help to identify many different functions in the body – and for this reason, anyone would get benefit from doing an Organic Acids Test.
OAT test is great for:
- Chronic illness – many people with chronic health conditions like chronic fatigue, fibromyalgia, mold toxicity, Lyme disease, autoimmune conditions – or any other chronic health issue
- Autism, ADHD, Schizophrenia and other mental health problems – not just because of the neurotransmitter metabolites but often these conditions are made worse by bacteria or candida overgrowth, or mitochondria issues
- Digestive issues – asessing markers for detoxification, bacteria overgrowth, candida and oxalates
- Athletes and biohackers – optimizing mitochondria function, fatty acid metabolism and nutrient deficiencies can help optimize performance and recovery
- Disease prevention – by detecting nutrient deficiencies, gut issues, detoxification and metabolism problems before they cause illness
Most Common Symptoms when OAT should be performed
8 Reasons Why Organic Acid Test Is One of My Favorite Tests
- It only requires a urine sample so it is easy to do, even for people who don’t like needles, and it’s easy for children to do too.
- It measures the function of the Citric Acid cycle, which is how your body makes energy! Each step of this process requires certain vitamins and nutrients and by identifying which aspects of the cycle are not working optimally we know what nutrients are needed. If you have fatigue issues this may be the key to identifying why and if it is connected to mitochondrial dysfunction.
- Carbohydrate metabolism is another important aspect and this section of the test can be helpful if you are having energy issues, poor blood sugar control or your an athlete wanting to optimize performance.
- Methylation is something that is becoming a big thing in health and wellness, many people are now taking advantage of 23andme to get their genes tested and find out how their genes affect their health. One important gene is MTHFR which affects folate metabolism, this test measures how well your cells are using folate and vitamin B12 which is another important component of methylation. Blood tests show how much folate and B12 is in the blood but your cells may not be able to use it so the Organic Acid testing is more accurate at identifying deficiencies.
- Oxidative stress is one of the driving factors behind inflammation and we can measure glutathione recycling and the body’s ability to produce Co-enzyme Q10.
- Bacterial infections and Candida are also causes of inflammation and one of the driving forces behind digestive problems but also skin issues, fatigue, anxiety, behavior problems and many other health issues.
- Organic acid testing measures fat metabolism, if you are having trouble losing weight this might be an issue for you. Or if you have adopted a high fat diet but still feeling tired, this may mean that you are lacking nutrients like the amino acid acetyl-l-carnitine to help turn fat into energy.
- The Organic Acids test measures the metabolites of the neurotransmitters dopamine, serotonin and adrenaline, this can help to identify the cause of health issues like anxiety, depression, and insomnia.
How to Do the Organic Acids Test?

The Organic Acids Test is a simple at-home test that only requires the collection of urine, and if you have a young child or a child with special needs the Mosaic lab can provide an easy solution for collection.
Your Organic Acid collection kit will include a urine collection cup and detailed instructions – you will need to collect 10mL of first-morning urine before any food or drink is consumed, and freeze this sample until it is ready to ship.
Certain compounds can increase a couple of the biomarkers and give false positives so following the instructions is important for accurate results. For 48 hours before you collect the urine sample, you should avoid apples, grapes, raisins, pears, cranberries, and the juice of these fruits. You should also avoid arabinogalactan, Echinacea, reishi mushrooms, and ribose supplements for 48 hours before collection.
I also recommend cutting out non-essential vitamins and minerals for the 48 hours before collection, this helps to get an accurate assessment of the vitamins that are assessed in the Great Plains test.
The samples are sent back to the lab in the provided pre-paid postage box – shipping is included in the U.S and if you live in other countries I recommend the Vibrant Wellness OAT test as they have the best international shipping rates.
Organic Acids Test Interpretation
Let’s look at some of the key sections of the Organic Acids report to help you understand how to interpret the results.
The first section of the test looks at 18 different markers that assess mold, fungal/ candida, and bacterial overgrowth.
Mold Markers on the OAT Test
Mold toxicity is associated with a whole range of chronic illnesses, and for many people, it can take years to diagnose.
Mold symptoms include Chronic fatigue, brain fog, fibromyalgia, recurrent infections, headaches, chronic digestive issues, and joint pain.
An Organic Acids Test can not only help to identify potential mold toxicity, but also assess whether there is also whether the mitochondria function can also be contributing to the fatigue.
The Visual Contrast Sensitivity test and a Mycotoxin test are also beneficial when assessing for mold.
Several of the markers on the test indicate mold toxicity.
- 5-Hydroxymethyl-2-furoic and Furan 2,5-dicarboxylic (Markers 2 and 4) are byproducts of Aspergillus and other fungal species. This can indicate that Aspergillus mold from food or water damage is growing in the digestive system.
- Elevations in Furancarbonylglycine can also indicate mold.
- Always take into account other signs and symptoms, along with other lab results before treating for mold.
Candida and Fungal Markers on the OAT Test
Arabinose is the most common marker indicating the presence of Candida, this is a more sensitive test than stool tests like the G.I Map test which only assesses for candida overgrowth in the large intestine.
Arabinose is a metabolite of candida, and high levels of candida can cause fatigue, brain fog, digestive issues, and skin conditions.
High Tartaric Acid and Tricarballylic Acid can also be elevated with Candida, and it is always important to assess all of the Organic Acids as a whole before beginning a treatment plan for candida.
Dysbiosis Markers on the OAT Test

The Organic Acids test also evaluates intestinal bacteria, distinguishing between beneficial and harmful bacteria.
Bacteria in the gut produce metabolites that can be assessed with your Organic Acids results.
2-Hydroxyphenylacetic Acid (marker 11), 4 Hydroxybenzoic Acid (marker 12), and 4-Hydroxyhippuric Acid (marker 13) are all markers of intestinal bacterial overgrowth. Elevations in these markers are generally seen with digestion issues or the many different symptoms that dysbiosis of bacteria can cause.
Hippuric (marker 10) is a byproduct of phenylalanine breakdown and chlorogenic acid (coffee) breakdown (and this is why you have to stop coffee). High levels indicate intestinal bacterial overgrowth.
The Organic Acids detect specific toxic metabolites of Clostridia bacteria. The toxins released by Clostridia metabolites can inhibit neurotransmitter metabolism in the brain, in particular, the breakdown of dopamine can be associated with anxiety, ADHD, increased autism symptoms and increased mental health issues in general.
Clostridia is associated with gut dysfunction including IBS symptoms, Crohn’s disease, and ulcerative colitis. Clostridia can also be a factor in chronic illnesses and neurological disorders.
4-Hydroxyphenylacetic (marker 15) indicates C. difficile, C. stricklandii, C lituseburense & others. HPHPA (marker 16) and 4-Cresol (marker 17) are clostridia markers.
Candida and bacteria overgrowth often occur together and they need to be brought back into balance to improve overall health. Tests like the Vibrant Wellness Gut Zoomer test combined with the Organic Acids results can help to work out the optimal way to treat these infections, as often treatment needs to be a specific step by step process rather than just taking high doses of herbs and doing a strict diet.
Oxalate Metabolites on the OAT Test

High oxalates are commonly associated with kidney stones, having high oxalate levels can increase your likelihood of having kidney stones, and people who have had kidney stones describe this as the most painful experience ever.
Oxalates can be found in many healthy foods like spinach, beet leaves, chocolate, peanuts, tea, berries, and nuts. These can all be very healthy foods so you don’t have to stop eating them, but if you have high levels of oxalates you may need to modify your consumption, especially if you have previously had kidney stones.
High oxalates can also be caused by mold or yeast overgrowth in the body, so you need to assess the levels of markers 1 to 9 on the Great Plains OATs test to assess if they could be contributing to your high oxalate levels.
A B6 deficiency can also contribute to high oxalate levels, this can also be assessed on the test by checking the B6 marker as well as Kynurenic acid. Oxalates can also inhibit the absorption of key minerals like calcium, magnesium, iron, and zinc.
Besides oxalates being one of the main causes of kidney stones they are also implicated in heart disease and joint pain.
Mitochondria Function and the Organic Acids Test

The mitochondria are like your cell batteries, and if they are not working optimally it can feel like you have a flat battery!
Markers 22 to 32 on the Organic Acid test assesses for mitochondria function.
Symptoms like learning difficulties, fatigue and fibromyalgia can be caused by problems with mitochondria function, but why do the mitochondria not work optimally?
This can be caused by mold, yeast and bacteria overgrowth, infections from a virus such as EBV or CMV, or tick-borne infections like Lyme disease, heavy metals, and environmental toxins can also affect mitochondria.
The OAT test assesses the metabolites of the Citric Acid Cycle, which is the different steps that occur in the mitochondria to make ATP (energy).
High levels of the organic acid markers indicate dysfunction in one or more of these steps in the production of ATP, and this can indicate the need for more nutrients such as the B group vitamins, amino acids, Co-enzyme Q10, lipoic acid, or D-ribose.
It is important to look at the mitochondrial markers as a whole and not treat individual imbalances, you also need to affect the gut health markers along with fatty acids metabolism which is also important for energy production.
7 Ways to Support a Healthy Mitochondria

Neurotransmitter Metabolites on the OAT Test

It is important to remember that when you are assessing the metabolites of the neurotransmitters dopamine, norepinephrine and serotonin on the OAT test these are not specifically assessing the levels of these neurotransmitters in the brain.
While these neurotransmitters are important in the brain the whole autonomic nervous system uses neurotransmitters, in fact, there is more serotonin produced in the gut than the brain. There is no perfect test to assess neurotransmitter levels in the brain so it is important to take into account your signs and symptoms along with the results.
But you can still use these markers, along with the Organic Acid markers that assess gut function, mitochondria, and nutrient deficiencies to help treat health conditions that affect the nervous system and mental health in general.
Markers 33 to 40 on the Great Plains Organic Acid Test help with the understanding of the neurotransmitters.
Quinolinic and kynurenic are tryptophan metabolites, low B6 can be a factor in reducing tryptophan conversion to 5HTP and serotonin, and can increase the conversion of tryptophan to quinolinic acid and kynurenic acid which are both neuroinflammatory. High levels of inflammation can cause or worsen behavioural problems and mood issues.
Abnormal organic acids results are seen in autism, ADHD, depression, anxiety, and dementia.
This makes the Organic Acids Test one of the best options for assessing the underlying causes of learning difficulties, behavioral problems and mental health issues.
Fatty Acid Metabolism and the OAT Test

Markers 42 to 49 on the urinary organic acids report assess for the levels of ketones and fatty acid oxidation.
These markers assess whether you are in ketosis, which is a good thing if you are doing a ketogenic diet, and not a good thing if you are not as you may have issues metabolizing fats.
They also assess how well you are converting fatty acids into energy, this can be a great source of energy for our mitochondria and why a ketogenic diet can sometimes be a good idea when people have issues converting carbohydrates into energy in the mitochondria.
High levels of the fatty acids metabolites can indicate inflammation, oxidative stress or a deficiency in the amino acid acetyl-l-carnitine, or Vitamin B2.
Genetic factors can influence how well you convert fats into energy, in particular, the PPAR gene can help to identify how well your metabolism converts fats into energy.
The Organic Acids Test and the Keto Diet
The ketogenic diet has become very popular these days, for many years it has been used to treat conditions such as epilepsy. Now more and more people are doing the keto diet for weight loss, improve brain function, mental energy and preventing chronic health issues
Urinary Organic Acids can help to determine if you are in ketosis and how effective you are at converting fatty acids into energy.
Nutrient Deficiencies and the OAT Test

The Organic Acid test can be a good way to assess for specific nutrient deficiencies, in particular, the B vitamins. There is not one “perfect” test for vitamin and mineral levels and I often combine this test with blood testing to get a complete overview.
Markers 41 and 42 on the Great Plains OATs test indicate a possible folate or vitamin B1 deficiency. High levels of Uracil can indicate a folate deficiency, it can also indicate methylation problems and this is more likely to be an issue for people with the MTHFR gene mutation.
Markers 50 to 57 on the OAT test can indicate deficiencies in other B vitamins, plus coenzyme Q10 and Vitamin C.
Methylmalonic acid is a specific marker for B12 deficiency, sometimes your blood test may show adequate levels of B12 in the blood, but the OAT test measures if you have a B12 deficiency at a cellular level. Sometimes blood tests can show normal levels, yet you still have a clinical B12 deficiency because it is not getting to the cells.
Glutathione and Detox Markers on the OAT Test

Inborn Errors of Metabolism
Organic acids testing was originally developed to assess inborn errors of metabolism, these genetic disorders are rare but because they disrupt biochemical pathways they can cause severe symptoms.
These types of conditions where genetic factors have a major influence are one of the rare times dietary modification does not have a major influence on the outcome.
Diagnosis using mass spectrometry to assess amino acids and genetic disorders is usually done in a hospital setting, and while the Great Plains lab urinary organic acids testing can identify these types of genetic disorders it is not the main focus of our testing.
How To Improve Your Organic Acids Test Results?
Once you have done the urinary organic acids testing how do you implement changes, especially when abnormalities are detected?
Because the results can indicate deficiencies in particular nutrients this is often the first thing people address, and end up walking away with a pile of supplements, which may or may not work.
This is where it is important to assess the results as well as get a complete history of symptoms, diet, lifestyle and other factors to find out what the underlying cause of the imbalance is – rather than just taking a lot of supplements.
I like to address the gut function, potential yeast or mold overgrowth first because the levels of these microorganisms can be the underlying cause of why the other markers are out of balance with your results.
If fatigue is a major issue then looking at the mitochondrial markers and neurotransmitter metabolites is going to be important too, while the imbalance may be caused by gut issues it is often helpful to get energy metabolism working and clients feeling better as a priority.
Lifestyle factors like diet, sleep, and stress reduction is also important, supplements won’t replace a lack of sleep or a diet high in processed refined foods. Diet and lifestyle improvements should be the basis of any health program.
Organic Acid Test Cost
The cost of the Mosaic Laboratory OATs test is $345, or with a one-hour consultation through Planet Naturopath the cost is $445.
The cost of the Vibrant Wellness OATs test is $300 and you can purchase a consultation later if required.
Organic acid testing is good value considering how many different aspects of health that it can assess, plus you can find out information that you cannot check for on the standard pathology tests.
This does not replace doing a pathology test as this can still give valuable information, but for many people, the results come back “fine” and they are told everything is ok, even though they know something is wrong.
This is why the Organic Acids testing is so valuable when you are optimizing your health.
If you have any questions about the Organic Acids Test review, or if you have any questions about ordering the OAT test contact us.
Bottom Line
- If you’re lacking energy, struggling with your weight, digestive problems, mood disorders or other chronic health issues the Organic Acids assessment can help identify the underlying cause.
- If your an athlete or biohacker looking to optimize your performance the Organic Acid test can help to identify missing vitamins and nutrients to help improve your performance.
- The Organic Acid test is available in Australia, the U.S, and can be shipped worldwide.
